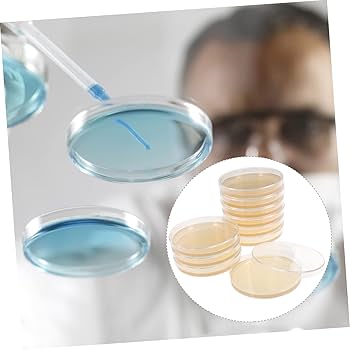
Agar Powder Hemobllo Agar Plates, Nutrient Agar Plate, Flat Sheet Glass Petri Dishes With Lids, Scientific Glassware Agar Jelly Petri Dish Agar Plates, Prepoured Agar Plates Prepoured Petri Plates Cell Tool 10pcs

AOOLMOL Dog Anxiety Vest And Coat, Vet Visits And






$ 5
- Order Calming Jacket For Dogs AOOLMOL Dog Anxiety Vest And Coat, Vet Visits And Thunder Vest For Anxious Dogs
Get it delivered as soon as today. Schedule your delivery in checkout.
More delivery methods in checkout
Free & Easy Returns In Store
Return this item within 7 days of purchase.
Get an immediate answer with AI
AI-generated from the text of manufacturer documentation. To verify or get additional information, please contact customer service.
Product Details
About This Product
Dog Anxiety Jacket, Skin-Friendly Dog Calming Vest - Dog Shirt for Thunder, Fireworks and ThunderShirt Calming Coat Jacket Dogs | Pets Coat only,other accessories demo in the picture are not included! Soft and comfortable materials,breathable and lightweight,efficient to make them feel safe. Calming Jacket For Dogs AOOLMOL Dog Anxiety Vest And Coat, Vet Visits And Thunder Vest For Anxious Dogs Eliminate anxiety and fear coat - effectively comfort your pet's mood when they feel scared or anxious,like swaddling a baby,adopts gentle pressure to keep them clam. Dog Anxiety Jacket Vet Recommended Calming Solution Vest for Fireworks, Thunder, Travel, & Separation, Find Details and Price about Dog Vest Dog Coats from Dog Anxiety Jacket Vet Recommended Calming Solution Vest for Fireworks, Thunder, Travel, & Separation - SPUPPS LIMITED Dog Anxiety Jacket Vet Recommended Calming Solution Vest for Fireworks, Thunder, Travel, & Separation, Find Details and Price about Dog Vest Dog Coats from Dog Anxiety Jacket Vet Recommended Calming Solution Vest for Fireworks, Thunder, Travel, & Separation - LIMITED#des#Dog Anxiety Jacket Vet Recommended Calming Solution Vest for Fireworks, Thunder, Travel, & Separation, Find Details and Price about Dog Vest Dog Coats from Dog Anxiety Jacket Vet Recommended Calming Solution Vest for Fireworks, Thunder, Travel, & Separation - LIMITED pply to those situations - thundering noise,fireworks,veterinarian check,car carriage,unknown barking and etc.Product Information
Customer Reviews
4.9 out of 5